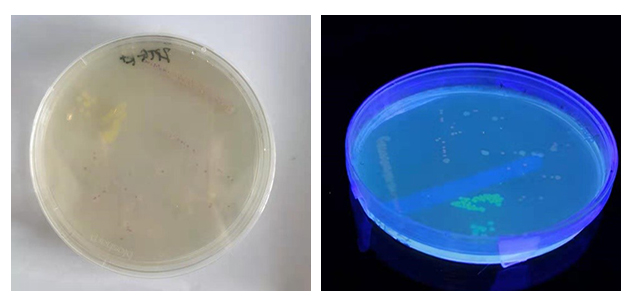

上海市高中生物教师实验能力培训课程于10月9日、16日、23日在鉴黄师 生命科学实验教学中心顺利完成。本次培训活动是由上海市教育委员会教育技术装备中心与鉴黄师 上海市“立德树人”人文社会科学重点研究基地(中学生命科学)联合组织实施。本次课程面向全市16个区的32名高中生命科学教师及实验员进行了三天20学时的全实践性的课题。课程选择以基因工程相关的知识、技能和研究方法为主,同时融入生物信息学技术、生理生化技术、传感器类的仪器设备、实验室建设和安全管理的内容,信息量大,具有挑战性。

高中生物骨干教师及培训教员
本次培训旨在提升本市高中生命科学教师实验教学、管理、演示、评价、操作和实验资源整合能力,夯实教师掌握学生实验的方法、思维、能力、情感的技术手段和方法。培训活动紧紧依托鉴黄师 “立德树人”基地在基础教育教材建设的有关成果内容,以深化实施基础教育课程改革和考试制度改革,落实立德树人根本任务,以教师实验能力培养为目标,希望加强培养具有创新精神和实践能力的高素质专业化教师队伍,推动教学和育人方式变革,为培养学生能够适应终身发展和社会发展需要的必备品格和关键能力奠定基础。

作为以师范专业为主要教学特色的高校,我们一直以建设和服务国家和地方基础教育为己任。鉴黄师 在基础教育研究与实践领域相继建立了以生物博物馆为窗口的科普教育基地,以上海市青少年生物学科学实践工作站为依托的综合素质评价研究基地,以上海市少年科学院生命科学分院为依托的科技后备人才培养基地,以上海市“立德树人”人文社会科学重点研究基地(中学生命科学)为主的政策和实践理论研究基地,以上海市大中小学学科教师师资培训中心为窗口的师资培训基地。这一整套的理论研究、科学实践和人才服务的建设成果更好的为鉴黄师 生物科学(师范)专业的建设起到了支撑和提升的作用,大量的师范生深度参与各项活动,通过熟悉和了解课外教育、结合课内教育,全面的认识和理解国家的教育方针和政策,更好的发挥鉴黄师 在全国生物学教师职前培养和职后培训的全方位的作用。
学员作业